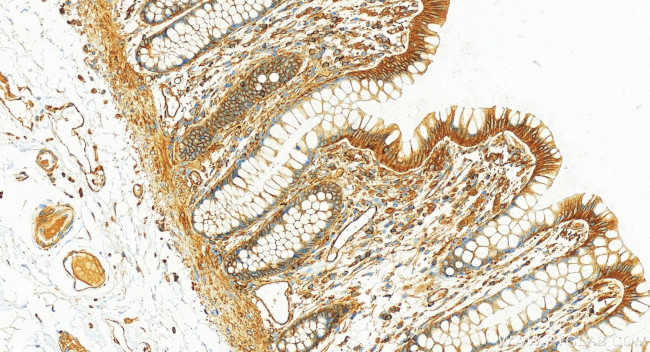
SEPT9 Antibody in Immunohistochemistry (Paraffin) (IHC (P))

Search
Proteintech
SEPT9 Recombinant Rabbit Monoclonal Antibody (2E7)
{{$productOrderCtrl.translations['antibody.pdp.commerceCard.promotion.promotions']}}
{{$productOrderCtrl.translations['antibody.pdp.commerceCard.promotion.viewpromo']}}
{{$productOrderCtrl.translations['antibody.pdp.commerceCard.promotion.promocode']}}: {{promo.promoCode}} {{promo.promoTitle}} {{promo.promoDescription}}. {{$productOrderCtrl.translations['antibody.pdp.commerceCard.promotion.learnmore']}}
产品信息
82844-2-RR
种属反应
宿主/亚型
Expression System
分类
类型
克隆号
抗原
偶联物
形式
浓度
纯化类型
保存液
内含物
保存条件
运输条件
产品详细信息
Immunogen sequence: RNEKAPVDFG YVGIDSILEQ MRRKAMKQGF EFNIMVVGQS GLGKSTLINT LFKSKISRKS VQPTSEERIP KTIEIKSITH DIEEKGVRMK LTVIDTPGFG DHINNENCWQ PIMKFINDQY EKYLQEEVNI NRKKRIPDTR VHCCLYFIPA TGHSLRPLDI EFMKRLSKVV NIVPVIAKAD TLTLEERVHF KQRITADLLS NGIDVYPQKE FDEDSEDRLV NEKFREMIPF AVVGSDHEYQ VNGKRILGRK TKWGTIEVEN TTHCEFAYLR DLLIRTHMQN IKDITSSIHF EAYRVKRLNE GSSAMANGVE EKEPEAPEM
靶标信息
The maf oncogene was identified by structural analysis of the AS42 avian transforming retrovirus genome. The Maf family is divided into two subclasses, large Mafs (vMaf, cMaf, MafB and Nrl) and small Mafs (MafF, MafK, and MafG). Both subclasses contain leucinezipper motifs, which allow homodimerization as well as heterodimerization with a variety of other bZip transcription factors. Large Mafs also contain an acidic transactivation domain absent in the small Maf proteins. Although they do not possess inherent transactivation activity, small Maf proteins can act as positive regulators of transcription by targeting transcriptionally active dimerization partners to specific DNA regulatory elements. Conversely, small Mafs can act also as negative regulators of transcription by recruiting transcriptional repressors or by forming homodimers that can replace active dimers. Human MafF was isolated in a yeast one-hybrid system from a human myometrium cDNA library. Human MAFF encodes a 164 amino acids proten. Like other small MAFF proteins, it contains an extended leucine zipper structure and lacks an N-terminal transactivating domain. The three small Maf proteins have been implicated in a number of physiological processes, including development, differentiation, haematopoiesis and stress response. Interestingly, these three proteins regulate the stress response via different mechanisms.
仅用于科研。不用于诊断过程。未经明确授权不得转售。
篇参考文献 (0)
生物信息学
蛋白别名: MLL septin-like fusion; MLL septin-like fusion protein; MLL septin-like fusion protein MSF-A; Ov/Br septin; Ovarian/Breast septin; Septin D1; Septin-9; SL3-3 integration site 1 protein
基因别名: AF17q25; KIAA0991; MSF; MSF1; NAPB; PNUTL4; SEPT9; SeptD1; SEPTIN9; SINT1
UniProt ID: (Human) Q9UHD8, (Mouse) Q80UG5
Entrez Gene ID: (Human) 10801, (Mouse) 53860